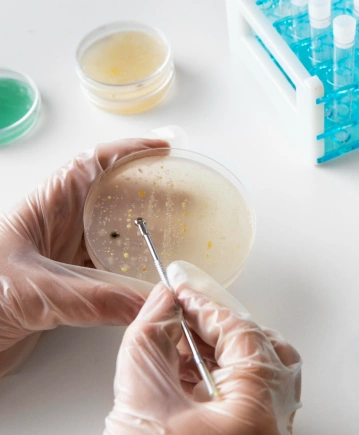
Mikrobiyoloji Testleri
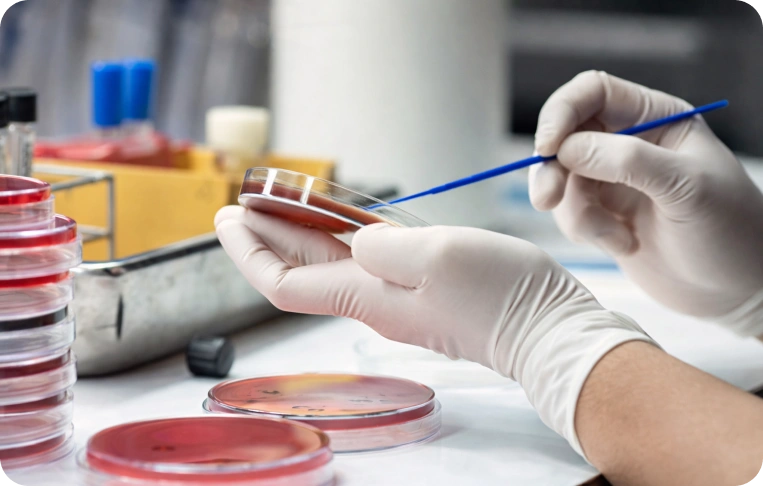
Mikrobiyoloji Testleri
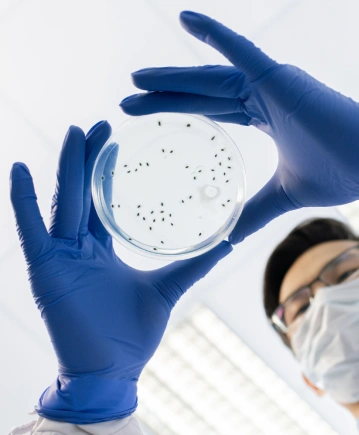
Mikrobiyoloji Testleri
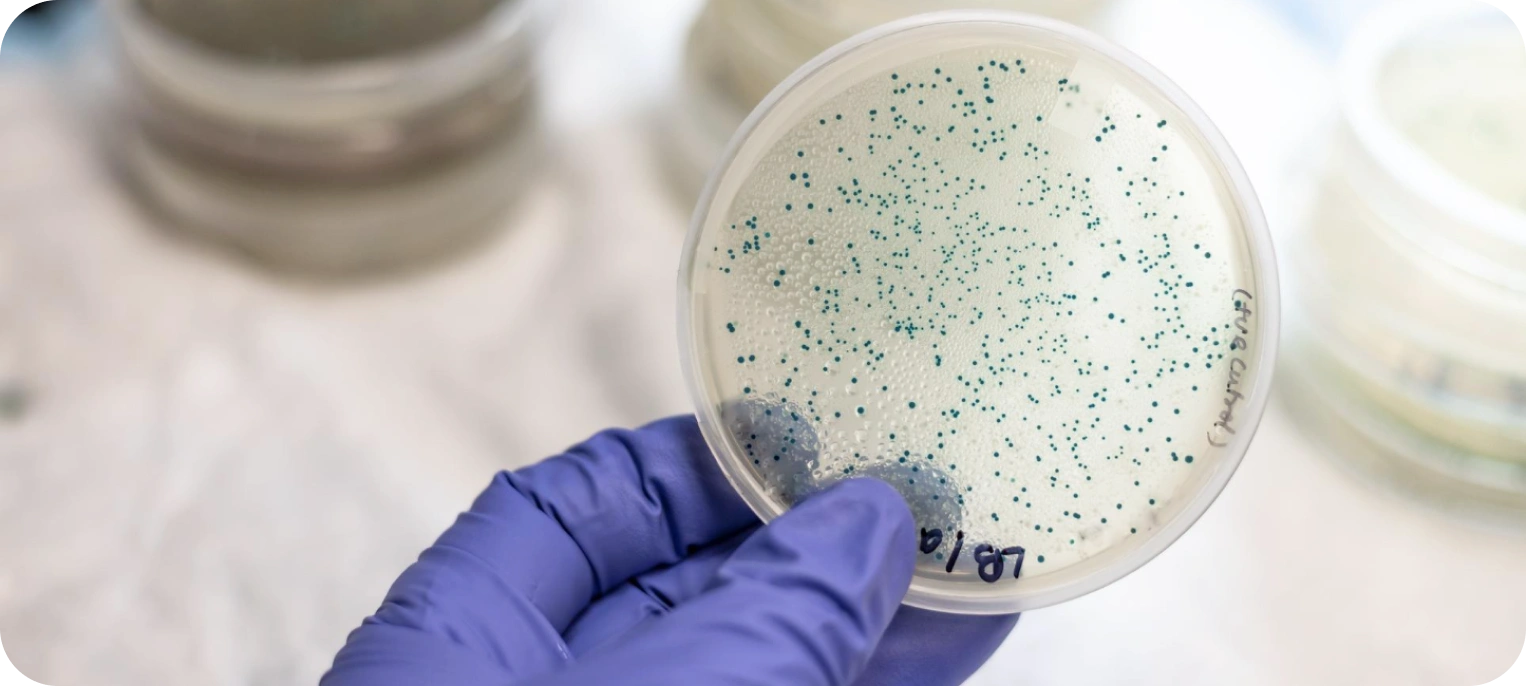
Mikrobiyoloji Testleri
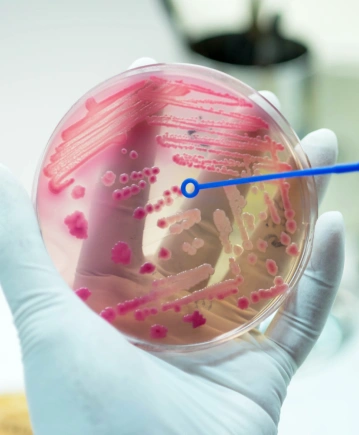
Mikrobiyoloji Testleri
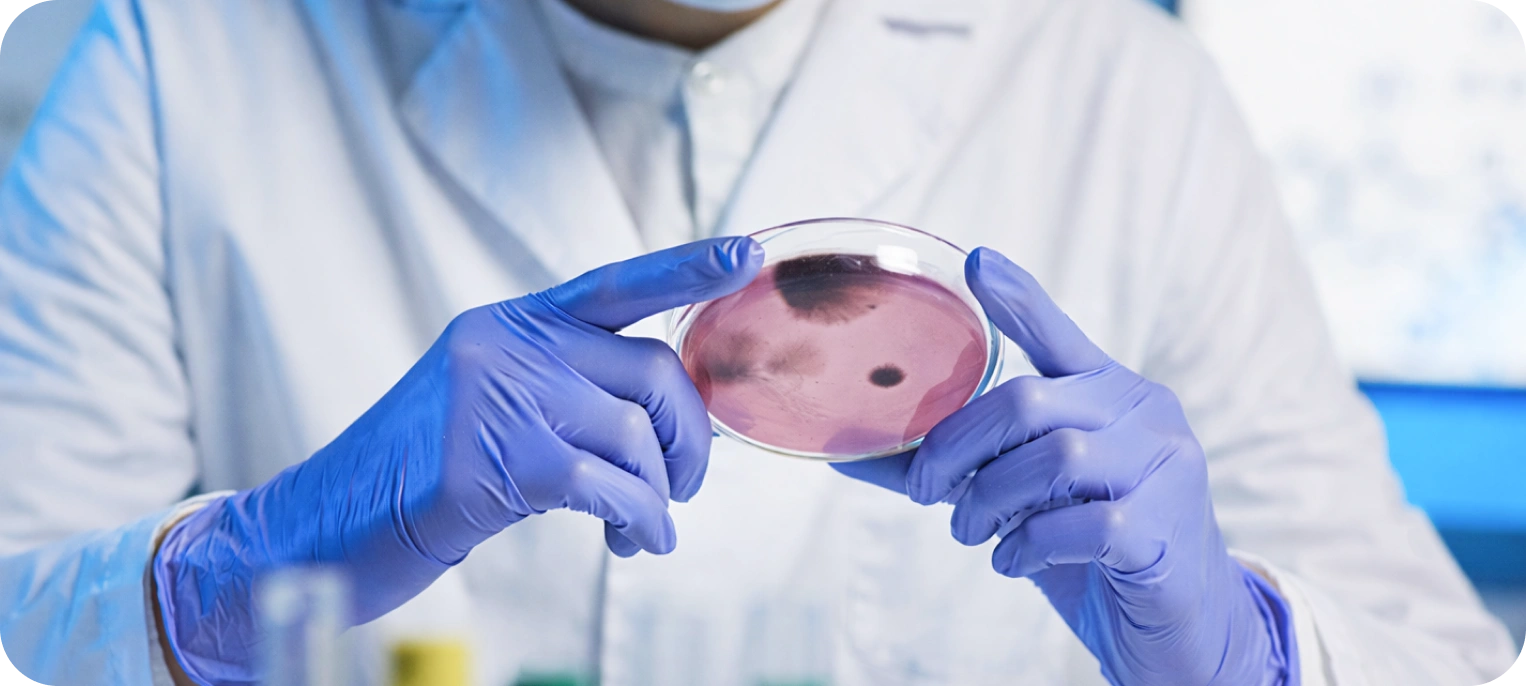
Mikrobiyoloji Testleri
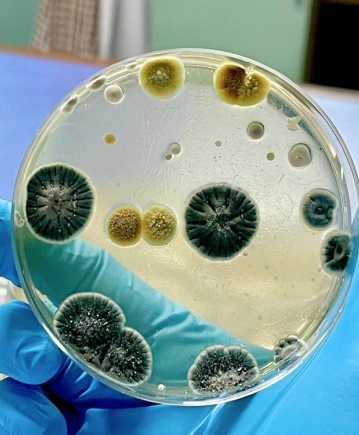
Mikrobiyoloji Testleri

Mikrobiyoloji testleri, vücutta enfeksiyona neden olabilen bakteri, virüs, mantar ve parazitleri tespit etmeye yönelik yapılan laboratuvar testleridir. Bu testler, alınan örnekler üzerinden mikroorganizmaların varlığını ve türünü belirlemeye yardımcı olur.
Enfeksiyonlar her zaman belirgin belirtilerle ortaya çıkmayabilir veya farklı şikâyetlerle kendini gösterebilir. Mikrobiyoloji testleri, bu durumların kaynağını daha net ortaya koymayı ve sürecin doğru şekilde izlenmesini sağlar. Günlük şikâyetlerden tekrarlayan enfeksiyonlara kadar birçok durumda bu testler, doğru değerlendirme için önemli bir temel oluşturur.
Aşağıda farklı ihtiyaçlara uygun Mikrobiyoloji Testlerimizi bulabilirsiniz.

Kültür testi, vücutta enfeksiyona neden olan bakteri ve mantarların tespit edilmesi için yapılan bir laboratuvar testidir. İdrar, kan, boğaz, yara, vajinal veya dışkı örnekleri üzerinden yapılan bu test sayesinde enfeksiyona yol açan mikroorganizmanın türü belirlenir.
Kültür testleri, özellikle sık tekrarlayan, uzun süren veya antibiyotik tedavisine yanıt vermeyen enfeksiyonlarda büyük önem taşır. Enfeksiyonun gerçek kaynağı belirlenerek doğru tedavi planlanmasına ve gereksiz ilaç kullanımının önlenmesine yardımcı olur.
Test sonuçları, örnek türüne ve kişinin klinik durumuna göre birlikte değerlendirilerek anlam kazanır.

Antibiyogram testi, kültür testinde tespit edilen bakterinin hangi antibiyotiklere duyarlı veya dirençli olduğunu belirlemek için yapılan bir laboratuvar analizidir. Bu test sayesinde enfeksiyona neden olan bakterinin hangi ilaçla en etkili şekilde tedavi edileceği netleştirilir.
Antibiyotiklerin bilinçsiz kullanımı, bakterilerin direnç geliştirmesine yol açabilir. Antibiyogram testi, en doğru antibiyotiğin seçilmesini sağlayarak hem tedavinin başarısını artırır hem de gereksiz ilaç kullanımını önler.

PCR enfeksiyon testleri, bakteri ve virüslerin DNA veya RNA’sını doğrudan tespit eden ileri teknoloji laboratuvar testleridir. Bu yöntem sayesinde mikroorganizmalar çok erken dönemde ve yüksek hassasiyetle saptanabilir. HPV, COVID-19, cinsel yolla bulaşan hastalıklar ve birçok viral enfeksiyonun tanısında yaygın olarak kullanılır.
PCR testleri, enfeksiyon henüz belirgin belirtiler oluşturmadan bile mikroorganizmayı tespit edebildiği için erken tanı ve hızlı tedavi açısından büyük önem taşır.



Serolojik enfeksiyon testleri, vücudun bakteri ve virüslere karşı ürettiği antikorları ölçen kan testleridir. Bu testler sayesinde kişinin bir enfeksiyonu şu anda geçirip geçirmediği, daha önce geçirip geçirmediği veya bağışıklık geliştirip geliştirmediği değerlendirilebilir. Hepatit, HIV, toksoplazma, rubella ve benzeri birçok enfeksiyonun tanı ve takibinde kullanılır.
Serolojik testler, özellikle kronik veya sessiz seyreden enfeksiyonların saptanmasında ve bağışıklık durumunun değerlendirilmesinde önemli rol oynar.



Parazitolojik testler, bağırsaklarda ve vücutta yaşayan parazitlerin tespit edilmesi için yapılan laboratuvar analizleridir. Bu testler sayesinde sindirim sistemi şikayetlerine, kilo kaybına, kansızlığa veya uzun süren ishale neden olabilen parazitler belirlenebilir.
Parazit enfeksiyonları bazen belirgin belirtiler vermeden ilerleyebilir. Parazitolojik testler, bu tür gizli enfeksiyonların saptanmasını ve doğru tedavinin planlanmasını sağlar.

Parazitolojik testler genellikle dışkı örneği üzerinden yapılır. Gerekli durumlarda perianal bant testi veya farklı örnekler de kullanılabilir. Alınan örnekler laboratuvar ortamında incelenerek parazitler tespit edilir.

Mantar (mikolojik) testler, cilt, tırnak, ağız, boğaz ve genital bölgelerde oluşan mantar enfeksiyonlarının tespit edilmesi için yapılan laboratuvar analizleridir. Bu testler sayesinde enfeksiyona neden olan mantar türü belirlenir ve doğru tedavi planlanabilir.
Mantar enfeksiyonları bazen uzun süre geçmeyen kaşıntı, kızarıklık, akıntı veya tırnak değişiklikleriyle kendini gösterebilir. Mikolojik testler, bu şikayetlerin altında yatan nedeni netleştirerek etkili bir tedavi süreci oluşturulmasına yardımcı olur.

Özel Birim Laboratuvarı olarak, tanı süreçlerinde ileri laboratuvar altyapısını, deneyimli uzman kadroyu ve kalite standartlarına dayalı çalışma anlayışını bir araya getiriyoruz.
Tüm analiz ve hizmet süreçlerinde doğruluk, güvenilirlik ve şeffaflığı esas alıyor; bireysel ve kurumsal ihtiyaçlara uygun çözümler sunuyoruz.

Evde, iş yerinde veya kurumlarda numune alımı için planlı, güvenli ve düzenli mobil kan alma hizmeti sunuyoruz.
İş yeri sağlığı, kurumlara özel test ve analiz ihtiyaçları için süreçlerle uyumlu ve sürdürülebilir laboratuvar çözümleri sağlıyoruz.

7/24
Hizmet

TÜRKAK ISO 15189 Tıbbi Laboratuvar Akreditasyon Sertifikası

Hızlı ve Güvenilir
Sonuçlar

10 Yıllık
Deneyim

100+ Kuruma Kurumsal Destek
Sıkça sorulan sorular bölümünde, laboratuvar hizmetlerimiz ve süreçlerimizle ilgili merak edilen konulara hızlıca yanıt bulabilirsiniz.
Vücutta ilaç, alkol veya farklı maddelerin varlığını incelemeye yönelik testleri kapsar.
Genetik yapı ile ilişkili taşıyıcılık ve kalıtsal özelliklerin incelenmesine yardımcı olur.